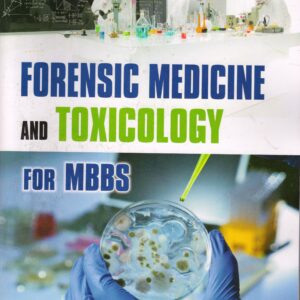
Forensic Medicine And Toxicology For MBBS 1st Edition

Shop
Showing 353–368 of 1085 results
-
Sale!

Fitzpatricks Therapeutics: A Clinician’s Guide to Dermatologic Treatment 1st Edition(McGraw-Hill Professional,Sewon Kang,English)
Original price was: ₹7,540.00.₹7,211.00Current price is: ₹7,211.00. Add to cart -
Sale!

FOGSI Focus on Micronutrients & Food Fortification 1st Edition(Evangel Publishing,Ritu Khanna,English)
Original price was: ₹1,495.00.₹1,209.00Current price is: ₹1,209.00. Add to cart -
Sale!

Forensic DNA Evidence Interpretation 2nd Edition(CRC Press,John S. Buckleton,English)
Original price was: ₹8,533.00.₹8,096.00Current price is: ₹8,096.00. Add to cart -
Sale!

Forensic Medicine & Toxicology 1st Edition(CBS Publishers & Distributors, K Tamilmani,English)
Original price was: ₹1,995.00.₹1,541.00Current price is: ₹1,541.00. Add to cart -
Sale!

Forensic Medicine & Toxicology Log Book Cum Practical Manual 2nd Edition( Jaypee Brothers Medical Publishers (P) Ltd,Gautam Biswas,English)
Original price was: ₹625.00.₹501.00Current price is: ₹501.00. Add to cart -
Sale!

Forensic Medicine & Toxicology Practical Manual 1st Edition(Elsevier Health Sciences, India,Shankar M Bakkannavar,English)
Original price was: ₹705.00.₹609.00Current price is: ₹609.00. Add to cart -
Sale!

Forensic Medicine and Toxicology (Theory, Practical Skills, VIVA) 4th Edition(Paras Medical Books Pvt Ltd,Khazi Mudabbir Ahmed,English)
Original price was: ₹1,495.00.₹1,290.00Current price is: ₹1,290.00. Add to cart -
Sale!
Forensic Medicine And Toxicology For MBBS 1st Edition(APC Books, Delhi,Anil Agarwal,English)n
Original price was: ₹995.00.₹807.00Current price is: ₹807.00. Add to cart -
Sale!

Forensic Medicine and Toxicology for Medical Students 6th Edition(Jaypee Brothers Medical Publishers (P) Ltd,Gautam Biswas,English)
Original price was: ₹1,450.00.₹1,190.00Current price is: ₹1,190.00. Add to cart -
Sale!

Forensic Medicine, Toxicology And Medical Jurisprudence 2nd Edition(CBS Publishers & Distributors,BV Subrahmanyam,SV Phanindra,English)
Original price was: ₹795.00.₹600.00Current price is: ₹600.00. Add to cart -
Sale!

Forensic Pathology of Asphyxial Deaths 1st Edition(CRC Press,Sudhir K Gupta,English)
Original price was: ₹9,111.00.₹6,700.00Current price is: ₹6,700.00. Add to cart -
Sale!

Forensic Pathology of Asphyxial Deaths 1st Edition(CRC Press,Sudhir K Gupta,English)
Original price was: ₹9,141.00.₹7,800.00Current price is: ₹7,800.00. Add to cart -
Sale!

Forensic Psychiatry 1st Edition(Jaypee Brothers Medical Publishers (P) Ltd,S Nambi,English)
Original price was: ₹2,095.00.₹1,790.00Current price is: ₹1,790.00. Add to cart -
Sale!

Forensic Psychiatry 2nd Edition(CBS Publishers & Distributors,BV Subrahmanyam,English)
Original price was: ₹695.00.₹490.00Current price is: ₹490.00. Add to cart -
Sale!

Forensic Toxicology 2nd Edition(CBS Publishers & Distributors,Vipul Ambade,English)
Original price was: ₹450.00.₹345.00Current price is: ₹345.00. Add to cart -
Sale!

Forensic Toxicology Principles and Concepts 2nd Edition(Elsevier – Saunders, Mosby, Churchill,Nicholas Lappas,English)
Original price was: ₹8,885.00.₹7,890.00Current price is: ₹7,890.00. Add to cart